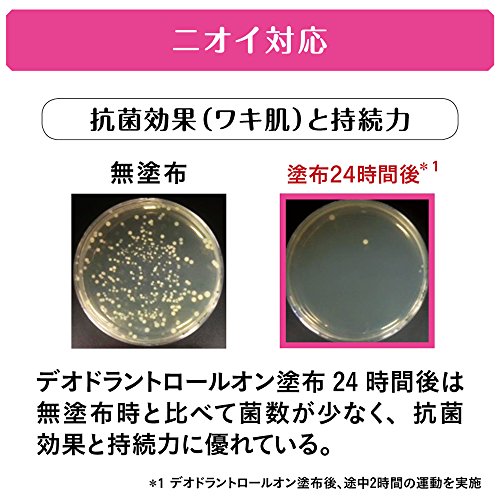

Product Name
시대《―데오》24 시대―데오24 deodorant 롤 온 무향료 40ml&씨트 세트(의약부외품)
Product Code: PROD380024364
Product Information
원본상품명:エ?ジ?デオ24 デオドラントロ?ルオン 無香料 40ml&シ?トセット(??部外品)
상품 사이즈 (폭×(길이)깊이×높이) :127mm×47mm×187mm
원산국:일본
내용량:40ml+10매
Technical Details
Product Details
Package Dimensions
Width : 4.92 inch
Height : 1.69 inch
Length : 7.2 inch
Shipping Weight: 4 ounce (View shipping rates and policies)
ASIN : B01C5GNKAI